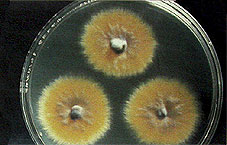
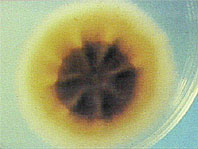

| WALDWEGE | Anfahrt | Eintritt | Sonderausstellungen | Veranstaltungen | Waldlieder | Links | Startseite | |
Sonderausstellung vom 2. Mai bis 16. Oktober 2005 in Fürstenberg/Havel | ||
| Sie sind überall zu finden – in der freien Natur ebenso wie in Häusern und Wohnungen. Sie besiedeln den Boden des Waldes und der Wiesen, unsere Lebensmittel und auch uns selbst. Über 120.000 Pilzarten wurden bislang in der Wissenschaft beschrieben, von typischen Großpilzen über Schimmelpilze bis zum
Hautpilz. Pilze dienen als Nahrung, sorgen dafür, dass unser Frühstücksbrötchen locker und das Bier lecker wird.
Sie begegnen uns als Heilmittel in der Medizin und als lästige Hautkrankheit. Die Ausstellung machte mit den recht unterschiedlichen Reichen dieser „heimlichen Weltmach” bekannt. Und der Besucher begegnete hier auch den Sporen, die sich – dem menschlichen Auge zumeist verborgen – über Luft, Boden und Wasser verbreiten. | ||
 |
 |
 |
| EINE KÜNSTLERISCHE NOTE erhielt die Ausstellung durch Kopien der ebenso lebendigen wie praxisnahen Aquarelle des Berliner Mykologen Erhard Ludwig, der auf diese Weise schon mehrere tausend Pilze dokumentiert hat.  |
VON KOPF BIS FUSS Die Deutschen sind sportbegeistert, tierlieb und reisefreudig – heißt es. Drei Eigenschaften, die eine Gemeinsamkeit haben: Sie führen zu einem Anstieg der Hautpilzerkrankungen. Vom Fußpilz bis zur Vaginalmykose – die Sporen lauern in Schwimmbädern, Saunen, Hotels und auch im eigenen Haushalt. Kommen noch Faktoren wie Stress, Rauchen oder falsche Ernährung hinzu, freuen sich die Hautpilze über einen neuen Lebensraum. | |
| Ausstellung der Pilzkundlichen Arbeitsgemeinschaft Berlin und Unterstützung des Naturparks Stechlin Ruppiner Land | ||
| WALDWEGE | Anfahrt | Eintritt | Sonderausstellungen | Veranstaltungen | Waldlieder | Links | Startseite | |